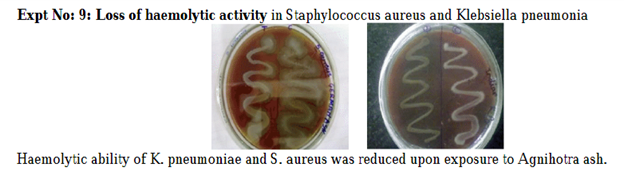

Published in PGurus
With the pandemic spread of Coronavirus (Covid-19) across the globe, parallel researches are taking place to cure the infection and develop vaccines to prevent the infection. A number of research findings are also pouring in from all sides to improve the immunity from the attack of this virus. But what goes missing is the realization that we indeed possess the most potent weapon against this virus in the form of the Vedic Homa called Agnihotra.
The name Agnihotra gained widespread attention soon
after the Bhopal Gas
Tragedy in 1984 when it was found that four or five families living near the Bhopal railway
station remained unaffected by the poisonous gas that surrounded them. Seeing the
inevitable staring at them the families decided to stay back and do Agnihotra Homa.
And wonder of wonders they were the sole survivors in that part of the city
affected by the leaking gas. This prompted researchers from Russia, Germany and
Poland to descend on the city to find out the causes for their survival. The
scientists of the Indian Defence and Research Department also evinced interest
in the research[1]
Following this, many research findings started
coming in of which I heard for the first time that cow dung has nuclear toxin
and poison resisting property when smeared on the walls and sprinkled every day
in the front of the house. Then came the incredible result on what saved the
survivors. It was Agnihotra
Homa done by them at the time of gas
leak. It was also said that they had been doing it regularly in the past.
Subsequently many tests were conducted and a model was evolved to get maximum
benefits.
By the 1990s, a group of dedicated volunteers
spanned across the country to spread the message of Agnihotra. It was through
one of them I learned to perform this Homa. In my observation I found the visible
organisms generally present in a house, namely cockroaches, lizards and spiders
disappeared after some months of practicing Agnihotra. In the course of few
years after regularly doing this Homa, I observed that Idly batter did not ferment
effectively even during peak summer season. The only plausible explanation I
could think was that the yeast naturally present in the air was wiped out. These
observations over the years are the basis of my deduction that doing Agnihotra can
be a good option to keep our surroundings sterile, especially in the current
crisis of threat from novel Coronavirus (Covid-19)
The following video gives a demonstration of how to perform
this Homa.
The Homa must be performed twice a day at sunrise
and sunset and on all days of one’s life. It takes less than 5 minutes to do
this Homa. Details of the materials used,
and instructions are given at the end of this article.
Is
Agnihotra proven to destroy virus?
Now the crucial question is - does this Homa kill Viruses
such as Covid-19? The researches that continue to happen have revealed that
Agnihotra fire and smoke remove biological, chemical and physical pollutants in
the air. The biological pollutants are pathogenic bacteria and viruses present
in the atmosphere around us. Several
studies have confirmed a drastic reduction in the bacterial count to less than
10% after 12 hours of doing the Homa, by which time the next round of the same Homa
must start. [2]
The discussion [3]
with Dr Ulrich Berk of Germany gives a detailed
exposition of various researches done by him and the effect of Agnihotra smoke
and ash on human health and soil health and also the potency of the Homa in
reducing pathogenic bacteria while not affecting beneficial bacteria. Some
intriguing facts not yet understood by science are also given by him for
further research.
Among the other researches, the one done by Nautiyal etal [4] on
medicinal smoke from the materials of the Homa is noteworthy. He observes that the “Absence
of pathogenic bacteria Corynebacterium urealyticum, Curtobacterium
flaccumfaciens, Enterobacter aerogenes (Klebsiella mobilis), Kocuria rosea,
Pseudomonas syringae pv. persicae, Staphylococcus lentus, and Xanthomonas
campestris pv. tardicrescens in the open room even after 30 days is indicative
of the bactericidal potential of the medicinal smoke treatment.”
One may be left to wonder why all these researches
talk only about destruction of pathogenic bacteria by the medicinal smoke from
Homa and there is no information on their activity on viruses. A possible
reason could be that bacteria can be cultured in artificial culture media and
observed for research, but it is not so for viruses. Viruses are parasitic and
need living cells to multiply. They attach to a living host-body for growth and
multiplication. Therefore, it is not possible to culture them in artificial
culture medium and need living host or complex cell/ tissue culture medium.
However, there are many researches, that describe the chemicals that can
destroy or de-activate the virus by targeting the structural cellular protein
components of the virus.
In the case of Coronavirus, it has been found out
that there is an “integral membrane
protein involved in several aspects of the virus’ life cycle, such as assembly,
budding, envelope formation, and pathogenesis.” [5] If
this membrane is damaged the virus material cannot sustain.
Based on this feature, breaking this membrane is proposed
as the best solution to destroy the Coronavirus (Covid-19). Since soap and
alcohol-based sanitizers break the membrane they are recommended for killing
this virus. An illustration from NewYork Times is
reproduced below to show how this works.[6]
Can
Agnihotra damage the protective protein layer of the
viruses?
This question gains importance in finding out
whether Agnihotra Homa can be a potent weapon against Covid-19.
The research done by Girish
Pathade and Pranay Abhang of Fergusson College of Pune[7]
shows loss of capsule formation of a pathogenic bacteria called Klebsiella
pneumonia when exposed to Agnihotra ash.
They also found out that the microbial content in
the air drastically reduced after exposure to Agnihotra fumes. The effect was
high within 10 feet distance from the Homa pot and reduced successively.
Ideally the effect was noticed within 30 feet distance from Agnihotra Homa pot.
The ability of the smoke of Agnihotra fire to
destroy the cell wall of bacteria must be applicable to the protein membrane protection
of the viruses too.
The experiments done by Rahul
Raveendran Nair [8]is
a big leap forward in this direction. His research indicates that Agnihotra
Homa does produce hydrocarbons in the air that “undergo partial oxidation and produce methyl alcohol, ethyl alcohol,
formaldehyde, acetaldehyde, and formic and acetic acids”. Here it is
noteworthy to observe that the alcohols that are released in the Homa smoke are
similar to the alcohol-based liquid hand sanitizers (with alcohol concentration
of 60%) that is recommended for inactivating the Coronavirus[9]
Pathade et al.6
(Fergusson College of Pune) used rice as an offering and observed reduction in
microbial content and loss of capsule formation in the bacteria. In RR Nair’s experiment7
Navadhanyas (9 types of grains) were used that led to the formation
of 17 compounds of alcohol in the air that remained in the air for a maximum duration
of 30 minutes. The following Table giving the list of hydrocarbon / ethyl
compounds is reproduced from his paper.
RR Nair further reports that “all these volatile substances spread out into the surrounding
atmosphere and are subjected to the photochemical reactions with sunlight and
form various compounds, which may be the reason behind the strict instructions to
perform agnihotra during daytime (sunlight is a major factor)” 7
He further notes, “.. partial oxidation of various
aromatic hydrocarbons certainly produces formaldehyde. Formaldehyde is the most
basic form of an antimicrobial aldehyde and is known to be a reactive
antimicrobial as it reacts
with proteins and peptides in microorganisms and kills them. While
agnihotra is being performed, a small amount of formaldehyde, along with water
vapor, is always produced.”
Hence, it is reasonable to conclude that regular
performance of Agnihotra Homa at a gap of 12 hours (sunrise and sunset)
everyday ensures continuous fumigation of the air around thereby preventing the
threat from harmful viruses such as Covid-19.
My earnest appeal
to scientists around the world working on containing this virus is to work on
the medicinal implications of this Homa and bring out an optimum combination to
destroy the Covid-19 virus.
Is
this Agnihotra Homa same as the Traditional Agnihotra
Homa?
This question arises due to the fact that
traditionally milk is offered in the fire though other kinds of offerings such
as grains including rice are permitted. Traditional Agnihotra Homa is a long
procedure done on the traditional Vedi (sacrificial altar) by boiling milk in Agnihotrasthaali (pot) in Grhya fire, drawing the fire
from Grhya to Ahavaniya and making the offerings in Ahavaniya fire. The
experimentally produced Agnihotra pot avoids this but retains the shape of the
Ahavaniya altar.
Though every householder is ordained to do Agnihotra
every day at sunrise and sunset, there are different schools of thought on when to perform: immediately before or soon
after sunrise or sunset or little later. But all texts are unanimous in stating that it must be
done close to sunrise and sunset time. The experiments had taken note of the
slight variations in time and arrived at a conclusion that exact sunrise and
sunset is the ideal time.
The use of rice as the offering is mandatory in
Aupasana which is also to be done at sunrise and sunset with the two line
mantra. But only two deities, namely Surya and Agni are worshiped in Aupasana.
The third deity Prajapati worshiped in Agnihotra Homa makes the experimentally deduced Homa a
simplified form of Agnihotra. Only Surya, Agni and Prajapati are regarded as
the deities of Agnihotra. [10]
Our Sutras advocate that Agnihotra can be done in
Grhya fire too. Examples include:
On bringing home the bride after marriage along with
the nuptial fire (domestic fire that will be used forever thereafter), the man
is ordained to do Agnihotra in that Grhya fire.[11]
“If he likes
he may (perform the sacrifice) with rice, barley, or sesamum.”[12]
“He should sacrifice in the
evening with (the formula), 'To Agni svâhâ!' in the morning with (the formula),
'To Sûrya svâhâ!' Silently the second (oblations) both times.”[13]
RR Nair’s experiment7 showed the
temperature levels needed for creating the desired compounds and oxides in the
air. The traditional Homa done in the traditional Vedi made of earth and other
materials prescribed by the texts attain the desired temperature with prolonged
procedures. The original experiment done on Agnihotra in the wake of Bhopal gas
tragedy seems to have taken this factor into account and after testing with
various methods had arrived at the specifications of a copper pyramid which
quickly transmits heat. The temperature noticed at the bottom, mid-level and
above the fire have been documented and it appears that the use of copper pot
of specified size matches with the temperature generated in the traditional
Vedi through prolonged procedure.
Yet another difference is the silent chanting of the
second mantra both in morning and evening Agnihotra. This pertains to the
offering to Prajapati. In the experimentally deduced Agnihotra Homa, this
mantra also must be uttered out. But both the times the mantras must be uttered
with specific intonation which one can find out in my demonstration video.
Now a brief account on the materials needed:
1. Pyramidal
Copper pot set containing 5 items. (This can be ordered online)
2. Cow
dung cake (dried)
3. Dried
twigs of any of the 5 trees – Banyan, Peepal, Bilwa (Aegle marmelos), Palasha
(Butea monosperma / பூவரசு), Udumbara (Ficus
racemosa / அத்தி )
4. Cow’s
ghee
5. Unbroken
and unpolished rice.
6. Oil
lamp to light. Gingelly oil or ghee lamps preferred.
7. 2
pieces of Camphor.
8. Sunrise
and sunset times of each day for one’s location.
The Homa must be done exactly at sunrise and sunset
every day. It can be done within 5 minutes. There is no caste, religion, gender
and age difference reflected in the results of Homa in the researches. However
the woman during her monthly periods is advised not to touch any of the
materials and not do the Homa. The results were found to be less when tested.
Only 2 mantras are found to give the maximum
benefits when they tested with all the mantras. They tested in different
languages and with meanings, but none of them produced the same result as was
done in Sanskrit mantra.
They must be recited in a particular intonation as
demonstrated in the video.
The morning mantra:
Suryaya
Svaha/ Suryaaya idam na mama//
Prajapataye
Svaha / Prajapataye idam na mama//
The evening mantra
Agnaye
Svaha/ Agnaye idam na mama//
Prajapataye
Svaha / Prajapataye idam na mama//
With an appeal to all to do this Homa every day for
one’s own health and for keeping the air clean around oneself, I expect newer
experiments with this Homa to combat the threat from deadly viruses like corona
virus.
In the experiments done by scientists after the
Bhopal gas tragedy it was detected through Kirlian
photography that the practitioners of Agnihotra had developed healthy ‘Aura’.[14] Healthy
aura gives rise to mental peace and heightened awareness of the Self.
Let everyone perform this simple Homa and live
happy and healthy.
Lokah Samastah Sukhino Bhavantu!
[1] “Agnihotra”
Sura Books Page 2
[2]
“Scientific aspects of Agnihotra: Purification of the atmosphere by the
Agnihotra - Part 1. (2018) https://www.agnihotra.org/2018/02/16/scientific-aspects-of-agnihotra-purification-of-the-atmosphere-by-agnihotra/
[4]
“Medicinal smoke reduces air-borne bacteria” Journal of Ethnopharmacology
(2007)
Volume 114, Issue 3, 3 December 2007, Pages 446-451 https://doi.org/10.1016/j.jep.2007.08.038
[5] “Coronavirus
envelope protein: current knowledge” Dewald Schoeman & Burtram C. Fielding
Virology Journal volume 16, Article number: 69 (2019) https://virologyj.biomedcentral.com/articles/10.1186/s12985-019-1182-0
[7]
“Scientific study of Vedic Knowledge Agnihotra”, G. R. Pathade, Pranay Abhang
Department of Biotechnology, Fergusson College, Pune
Published in Bharatiya Bouddhik Sampada A Quarterly
Science Research Journal of Vijnana Bharati 43rd – 44th Issue, February - June
2014
[8] “Agnihotra
Yajna: A Prototype of South Asian Traditional Medical Knowledge” Rahul
RaveendranNair
Journal of Acupuncture and Meridian Studies
Volume 10, Issue 2, April 2017, Pages 143-150
[9] CDC
Statement for Healthcare Personnel on Hand Hygiene during the Response to the
International Emergence of COVID-19 https://www.cdc.gov/coronavirus/2019-ncov/infection-control/hcp-hand-sanitizer.html
[10]
Asvalayana Grhya Sutra, I-2-2.2
[11]
Asvalayana Grhya Sutra, 1-9-4.4
[12]
Asvalayana Grhya Sutra, 1-9-6, Sâṅkhâyana-Grihya SutraI, I, 12; Âsvalâyana-Srauta Sutra, II, 2.
[13]
Asvalayana Grhya Sutra, 1-9-7
[14] “Agnihotra”
Sura Books, page 4
UPDATE on 23rd June 2020
UPDATE on 23rd June 2020
It is coming to be known that hemoglobin count gets
reduced with progression of Covid 19 attack in a person. Researches have shown
that this virus inhibits the ability of the RBC to attach iron. It ruptures the RBC. This is called
'haemolytic" activity. Certain bacteria such as Staphylococcus and
Klebsiella pneumoniae are found to cause 'haemolytic" activity, clinically known as autoimmune haemolytic anaemia (AIHA).
The same syndrome of AIHA is reported in Covid 19 cases.
In this regard let me add another research by Girish Pathade and Pranay Abhang of Fergusson College of Pune, quoted in the
article . They tested for haemolytic activity on these bacteria and found that
the bacteria lost haemolytic activity upon exposure to agnihotra ash (reproduced below). This means Covid 19's propensity for haemolytic activity also will be affected by Agnihotra.
Based on this it is suggested not to disturb the ash once the homa is over. Let the homa ash continue to remain in the kunda for 12 hours until the next homa starts.